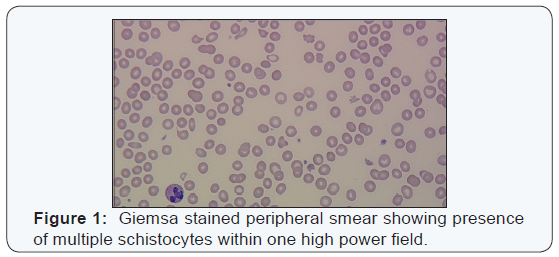
Click here to view Large Figure 1

Clopidogrel Induced Thrombotic Thrombocytopenic Purpura
Rashmika Potdar* MD, Dipa Avichal DO, Kamran Mohiuddin MD, Vivian Arguello MD, Gabor Varadi MD
Albert Einstein Medical Center, USA
Submission: December 06, 2016; Published: December 13, 2016
*Corresponding author: Rashmika Potdar, Albert Einstein Medical Center Philadelphia, 5501 Old York Road Philadelphia, PA 19141, Philadelphia, USA
How to cite this article: Rashmika P M, Dipa A D, Kamran M M, Vivian A M, Gabor V M. Clopidogrel Induced Thrombotic Thrombocytopenic Purpura. J Cardiol & Cardiovasc Ther 2016; 2(3): 555588. DOI: 10.19080/JOCCT.2016.02.555588.
Abstract
Clopidogrel is commonly used drug in cardiology practice. Though apparently benign, it can rarely caus! e Thombotic Thrombocytopenic Purpura (TTP). Mechanism of action by which Clopidogrel causes TTP is different than usual. This makes the situation more interesting. Here we are presenting a case of NSTEMI who developed TTP after Clopidogrel. Diagnosis is purely clinical. Early diagnosis and plasmapheresis is lifesaving. A 66-year-old female presents to the hospital for new onset of chest pain. After laboratory and diagnostic workup, NSTEMI was diagnosed. Patient underwent catheterization where triple vessel disease was found, only amenable to CABG. During treatment of NSTEMI, patient received Clopidogrel for 2 days, which was subsequently held in preparation for CABG. After CABG, Clopidogrel was restarted and patient started having dramatic decreases in platelet count and haemoglobin requiring blood transfusions. Peripheral smear showed schistiocytes,polychromasia , nucleated red blood cells and low platelets. Because of persistent platelet drop, haemolysis and uraemia concern for TTP was raised. As Clopidogrel was recently started, it was considered the etiological factor. Clopidogrel was held, and plasma exchange was immediately started with steroid therapy while ADAMSTS-13 levels were pending. After 7 days of plasma exchange and 5 days of steroids, platelet counts and haemoglobin subseq! uently increased to appropriate levels. ADMASTS-13 levels came back normal indicating different mechanism to induce TTP than what has been widely studied in the literature..
Keywords: CKD 5: Chronic Kidney Disease Stage 5; MAHA: Microangiopathic Hemolytic Anemia; PCI: Percutaneous Coronary Intervention; TTP: Thrombotic Thrombocytopenic Purpuran
Patient Case
A 66 year-old-female with past medical history of chronic kidney disease stage 5 (CKD-5) not on hemodialysis, hypertension, diabetes mellitus type 2 presents to the emergency department with new onset chest pain and shortness of breath for the past two weeks. Vitals revealed patient to be saturating 86% on room air, requiring 3L of nasal cannula. All other vitals stable. On physical exam, patient had a jugular venous distention. Bilateral course rhonchi were heard on pulmonary exam. All other physical exam findings were normal. Laboratory results revealed hemoglobin of 8.9, which was patient’s baseline, platelet count of 266, creatinine of 6.2. Patient had a troponin elevation and T wave inversion in lateral leads. Due to concern for NSTEMI, patient was given Aspirin 325mg and Clopidogrel 75mg and taken for left heart catheterization the next day.
Patient, on day of catheterization was given 300mg of Plavix. Catheterization revealed triple vessel disease, amenable to CABG. Plavix was held for 9 days as patient was awaiting platelet function to improve for CABG. During the interim, patient had worsening renal function secondary to contrast load during catheterization, and hemodialysis was started. Patient was also requiring packed red blood cell transfusions for hemoglobin of 7. EPO was also started because of low iron and TIBC levels secondary to chronic disease from CKD. CABG was performed on day 10 of hospital stay. Patient tolerated surgery well and clopidogrel was restarted after surgery was performed.
The evening of CABG, patient had a significant platelet drop to 89 with no signs of bleeding. Patient did start to have easy bruising of extremities. There was also concern for a concomitant thrombogenic process secondary to patient’s dialysis line forming clots twice within a three day period. 4T score was 4. Heparin was held and Heparine Induced Thrombocytopenia work up was sent. Platelet continued to drop on Argatroban, which made us to think of another diagnosis as etiology. A peripheral smear was performed which showed numerous schistocytes. LDH was 572, Reticulocyte count was 4.67, Haptoglobin was 46. Because of thrombocytopenia, hemolytic anemia and worsening kidney function, TTP was a concerning differential diagnosis, especially after recent administration of clopidogrel.
Clopidogrel was immediately held and patient was started on plasma exchange therapy as ADAMST-13 was pending. Prednisone 80mg daily was started as well. Mean time HIT antibody came back positive but Serotonin Release Assay was negative. Platelet count went up subsequently in the next few days with Plasma exchange with after 7 days of plasma exchange therapy and 5 days of prednisone therapy, platelet count went to 122 and hemoglobin 9.5 without any need to additional blood transfusions. Peripheral smear revealed decreased schistocytes and increased platelets. ADAMTS-13 was found to be normal.
Discussion
TTP is known as a thrombotic microngiopathic syndrome, which can be caused acquired or hereditary etiology. The acquired form, as seen in this patient, is caused by auto antibodies that form against the metalloprotease ADAMTS-13 [1], which ultimately cleaves von-willibrand factor, a large multimer. A decrease in this protease activity allows this large multimer to bind to platelets and in turn, creating microthrombi, thrombocytopenia and microvascular occlusion [2]. Microangiopathic hemolytic anemia (MAHA) is also seen in the form of schistocytes as erythrocytes are damaged by the large multimer-platelet complexes. TTP classically includes a pentad of features: MAHA, thrombocytopenia, fever, renal abnormalities and neurologic disturbance [3]. In this case, the TTP was medication induced secondary to clopidogrel usage. According to the Oklahoma TTP-HUS registry in 2013, in the adult population, TTP is seen in 3 cases per one million adults, 76% of whom were females [4].
Clopidogrel is an anti-platelet medication commonly used in conjunction with aspirin mainly for patients during acute coronary syndrome or after percutaneous coronary intervention (PCI) to prevent re-instant thrombosis. The medication works by irreversibly blocking the P2Y12 component of the ADP receptors on the platelet surface, which ultimately prevents platelet aggregation [5]. Clopidogrel has widely replaced Ticlodipine, another structurally similar antiplatelet medication, due to its larger safety profile [6]. Ticlodipine was found to have elevated incidences of TTP, about 1 in 1600 patients treated. In contrast, clopidogrel induced TTP has only been noted in a few case reports [7]. It has been reported by a pharmaceutical supplier that the rate of clopidogrel induced TTP is about 12 in 1 million patients receiving the medication [8].
The mechanism of action in clopidogrel induced TTP differs from what is normally seen. In contrast to low ADAMTS-13 secondary to an autoantibody reaction, there is normal protease activity in cases where clopidogrel is involved, as seen in our patient [9]. A study by Bennet et al exploring the different mechanism of thienopyridine associated TTP, 75% of patients that received clopidogrel are found to have an ADAMTS-13 level>15% at the time of diagnosis of TTP. The exact mechanism by which clopidogrel induces TTP has not been well studied. A theory of endothelial cell wall damage has been introduced. Because of normal levels of ADAMTS-13, endothelial cell wall damage allows the secretion of these large multimers of VWF, which have been studied in mouse models, inducing TTP [7]. The timeline for clopidogrel induced TTP also differs from other medication induced TTP’s. Signs of TTP are seen within a 2 week of receiving clopidogrel, which is in contrast to other thienopyridines in which TTP occurred within 2-12 weeks of medication administration [10]. This patient started presenting with TTP about 9 days after clopidogrel administration. This also strengthens the notion that patients diagnosed with TTP within a short amount cannot allow for auto antibodies to form against ADAMSTS-13, allowing another mechanism to cause TTP. Because of normal ADAMTS-13 levels, the diagnosis of TTP is primarily clinically based on symptomology and lab values (Figures 1 & 2).

Conclusion
Treatment for TTP should be started as soon as possibly secondary to the high mortality associated with TTP. Because clopidogrel induced TTP is very rare, management is mainly based on case reports and that of routine treatment for TTP. Clopidogrel should be immediately discontinued and plasma exchange therapy should be considered immediately. Survival amongst patients who received TTP was about 70% for those patients who received plasma exchange [9]. Plasma exchange therapy should continue until platelet count is over 150 thousand for at least 3 days. High dose steroids should also be started at the time of diagnosis and tapered once patient has a platelet count that has plateau to acceptable levels [9]. Our patient has received 7 cycles of plasma exchange therapy with improvement in platelet count to above 150 after day 4. Our case demonstrates the different mechanism that clopidogrel undergoes to cause TTP then what has widely been studied.
References
- George J, Cuker A (2016) Acquired TTP: Clinical manifestations and diagnosis. In: UpToDate, Post TW (Ed), UpTo Date, Waltham, MA.
- Voorhees P.M (2015) MKSAP 17-Hematology and Oncology. Philadelphia. American College of Physicians. Page 28.
- James N. George (2006) Thrombotic Thrombocytopenic Purpura. N Engl J Med 354(18): 1927-1935.
- Reese JA, Muthurajah DS, Kremer Hovinga JA, Vesely SK, Terrell DR, et al. (2013) Children and adults with thrombotic thrombocytopenic purpura associated with severe, acquired Adamts13 deficiency: Comparison of incidence, demographic and clinical features. Pediatr Blood Cancer 60(10): 1676-1682.
- Lexicomp Online® (2016) Clopidogrel: Drug Information, Lexi- Drugs®, Hudson, Ohio: Lexi-Comp, Inc.
- Berger PB, Bell MR, Rihal CS, Ting H, Barsness G, et al. (1999) Clopidogrel versus ticlopidine after intracoronary stent placement. J Am CollCardiol 34(7): 1891-1894.
- Zakarija, Anaadriana, Hau C. Kwaan, Joel L. Moake, et al. (2009) “Ticlodipine and Clopidogrel associated Thrombotic Thrombocytopenic Purpura (TTP): Review of Clinical, Laboratory, Epidemiologcal and Pharmacoviligance Findings (1989-2008).” Kidney Int Suppl 112: 20- 24.
- Clopidogrel (Plavix) [package insert] Bristol-Myers Squibb and Sanofi- Synthelabo; New York, NY: 2006.
- Jerry A. Rubano, Kwan Chen, Brianne Sullivan, James A. Vosswinkel, Randeep S. Jawa (2015) “Clopidogrel-Associated Thrombotic Thrombocytopenic Purpura following Endovascular Treatment of Spontaneous Carotid Artery Dissection.” J Neurol Surg Rep 76(2): e287-e290.
- Bennett CL, Kim B, Zakarija A, Bandarenko N, Pandey DK, et al. (2007) “Two Mechanistic Pathways for Thienopyridine-Associated Thrombotic Thrombocytopenia Purpura.” J Am Coll Cardiol 50(12): 1138-1143.






























